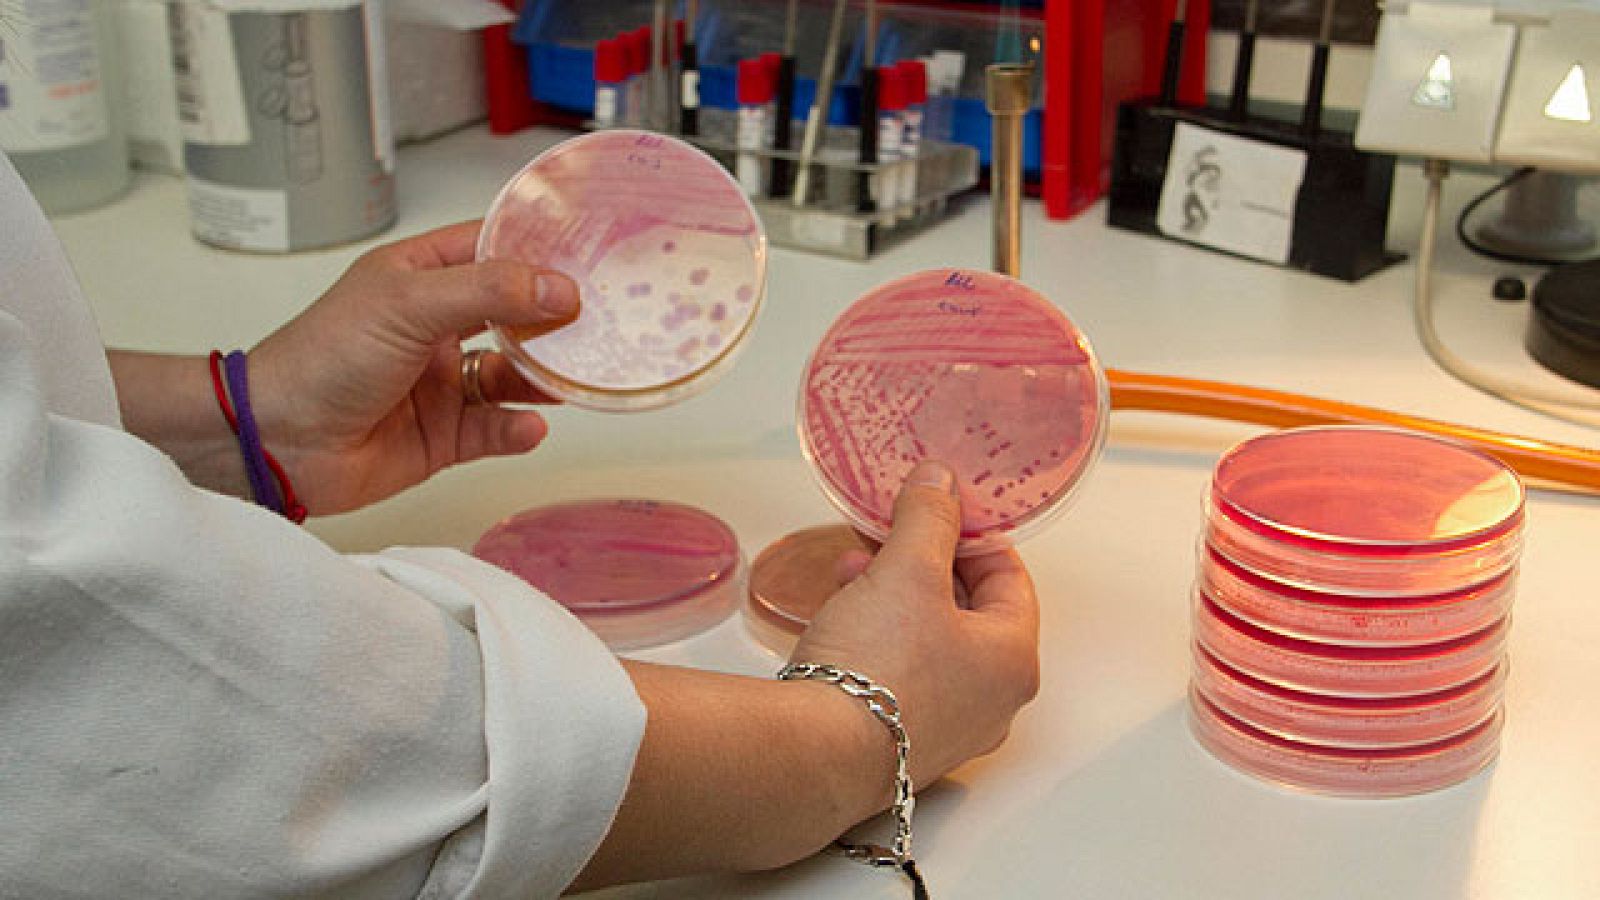
En España no ha habido ninguna infección por E. Cóli

Telediario 1
No hay afectados por E. Coli aquí
En España no ha habido ninguna infección por E. Cóli
04/06/2011 00:01:21